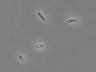

Accessioned in 2006.
=DSM 18378.
Desulfobulbus japonicus.
Type strain [6791,13530,13546].
Medium: 553; Temperature: 30°C; Anaerobic.

open link in new window

open link in new window
|
14043T <-- A. Ueki Pro1. Accessioned in 2006. =DSM 18378. Desulfobulbus japonicus. Type strain [6791,13530,13546]. Medium: 553; Temperature: 30°C; Anaerobic. |
 open link in new window |
open link in new window |
| Biosafety level | 1 | |
| Terms and conditions | Not applicable | |
| Export control (1) | No | |
| Distribution control in Japan (2) | No | |
| Genetically modified microorganism | No | |
| Technical information | - | |
| Additional information | - | |
| Domestic | B (Actively growing culture of a microbial strain that is not preserved as a dried culture / a microbial strain of which dried ampoules are not available) | |
| Overseas | B (Actively growing culture of a microbial strain that is not preserved as a dried culture / a microbial strain of which dried ampoules are not available) |
 Instructions for an order
Instructions for an order
 Go to JCM Top Page
Go to JCM Top Page
 Go to List of JCM strains
Go to List of JCM strains